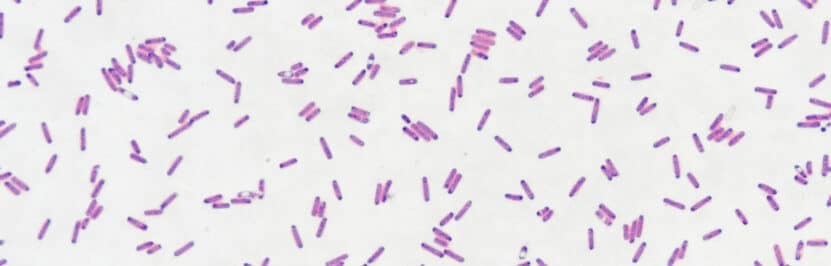

Biologické čištění odpadních vod
7.10.2020
Princip biologického čištění vody je postaven na odstraňování organického znečištění pomocí mikroorganismů, zejména bakterií. Proces probíhá v aktivačních nádržích (bioreaktory), kde...

Co je chlordioxid (oxid chloričitý/ClO₂), použití a výroba generátory chlordioxidu
25.7.2019
Chlordioxid neboli oxid chloričitý (ClO₂)je známý jako velmi účinné oxidační...

Clostridium perfringens
16.2.2017
Clostridium perfringens patří mezi nejobvyklejší lidské patogeny. Přítomnost v lidském organismu může způsobovat histotoxické infekce, plynaté gangrény, celulitis. Nejčastěji je však...

Enterokoky ve vodě
Enterokoky (Enterococcus) jsou přirozenou součástí střevní mikroflóry. Najdeme je ale i ve vodě, v půdě a na rostlinách. Tyto bakterie odolávají...

Brakická voda a její odsolování
4.5.2016
Brakickou vodou je myšlena ta voda, která má koncentraci solí na pomezí mezi mořskou a sladkou...

Uran ve vodě a jeho odstranění
Uran je stříbrně lesklý radioaktivní chemický prvek patřící mezi skupinu kovů nazývaných aktinoidy. Prvek byl nalezen Martinem Heinrichem Klaprothem v roce...

Kotelní kámen
11.3.2016
Kotelní kámen je mix několika minerálů, které se usazují na stěnách potrubí či nádob v níž dochází k ohřívání tvrdé vody....

Noroviry
28.5.2015
Noroviry byly objeveny v roce 1972 ve městě Norwalk v USA, ze kterého byl odvozen i jejich...

Hygienické zabezpečení vody
Hygienické zabezpečení vody provádíme dezinfekcí. Je to nezbytný krok k odstranění nežádoucích bakteríí a mikroorganismů z...

Limity Legionell ve vodě
Limity Legionell ve vodě stanovuje vyhláška č. 252/2004 Sb. kterou se stanoví hygienické požadavky na pitnou a teplou vodu a četnost...

Hypermangan v dezinfekci vody
2.5.2014
Manganistan draselný (lidově hypermangan) je silné oxidační činidlo, které má využití v lékařství, analytické chemii i úpravě vody. Dříve se používal...

Hodnotící limity pitné vody
29.4.2014
Voda může dle vyhlášky obsahovat vždy jen povolené množství nejrůznějších látek. Zde najdete jejich přehled včetně konkrétních parametrů. Vše platné pro...

Polychlorované bifenyly (PCB)
13.3.2014
Polychlorované bifenyly (PCB) je skupina látek, které zahrnují více než 200 různých...
Bakterie Bacillus cereus
12.3.2014
Většina členů rodu Bacillus cereus jsou saprofytické mikroorganismy, které můžeme najít hlavně v půdě, ve vodě, ve vzduchu a na...

Dichlordifenyltrichlorethan (DDT)
25.2.2014
Pesticid DDT je pravděpodobně nejznámějším případem přehnaného používání chemických látek...

Síran vápenatý
17.2.2014
Síran vápenatý se používá k regulaci kyselosti jako tzv. zpevňující látka. Obohacují se s ní látky vápníkem. Síran vápenatý je bílý...

Aktivní uhlí
13.2.2014
Aktivní uhlí (AC, Active carbon) je ideální prostředek (adsorbent) pro odstraňování fenolů z...

Tenzidy
Tenzid neboli surkfaktant je povrchově aktivní látka, která umí snižovat povrchovou energii. název “tenzidy” pochází z...

Trihalomethany
Trihalomethany (Trihalomethane) vznikají jako vedlejší produkt dezinfekce chlórem, kdy chlór reaguje s organickými látkami, které se volně vyskytují ve vodě a hrozí...

Améba – měňavka
25.6.2013
Améba neboli Měňavka je názvem pro jednobuněčný organismus, který je zařaditelný mezi kořenonožce. Tento organismus se pohybuje pomocí...

Sanace studní
25.3.2013
Obecně lze sanaci definovat jako přijetí opatření k nápravě škod. Sanace znamená odstranění příčin a následků způsobených...

Hydrogeologický průzkum
Hydrogeologický průzkum, hydrogeologický posudek, analýza vody, rozbor vody, to jsou vše výrazy se kterými se setkáte při stavbě studny nebo...

Co je destilovaná voda?
28.11.2012
Destilovaná voda je ta voda, jenž prošla procesem...

Uhličitan vápenatý
30.10.2012
Uhličitan vápenatý je bílá látka krystalického skupenství. Přírodní výskyt je v podobě vápence. Zahříváním se rozpadá při čemž vzniká oxid vápenatý...